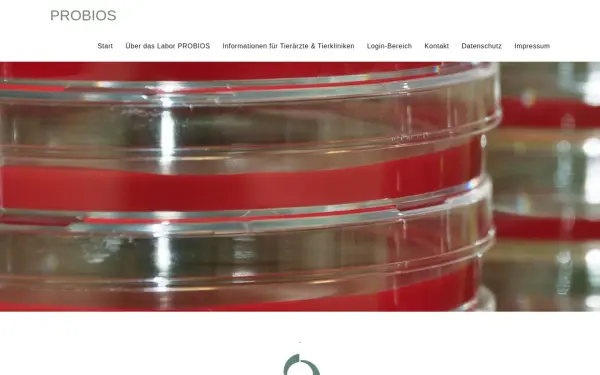
probios.de

probios.de
PROBIOS – Labor für mikrobiologische Diagnostik
Sprache: Deutsch
Charset: utf-8
Generator: Elementor 3.33.4; features: additional_custom_breakpoints; settings: css_print_method-external, google_font-enabled, font_display-auto
Robots-Anweisung: max-image-preview:large
Viewport: width=device-width, initial-scale=1
Sicherheit und Einstufung
Die Website enthält laut CLOUDFLARE keine bedenklichen Inhalte und kann sowohl von Minderjährigen als auch in der Arbeit genutzt werden.
Rechtliches / Kontakt
Impressum:
https://probios.de/impressum/
Kontakt:
https://probios.de/kontakt/
Der Betreiber dieser Domain befindet sich in 86899 Landsberg am Lech
Sämtliche Sub-Domains der Haupt-Domain
probios.de
probios.de
Verwendete Technologien
Apache ist eine freie und quelloffene, plattformübergreifende Webserver-Software.
Elementor ist eine Website-Builder-Plattform für Profis auf WordPress.
jQuery-Plugin, um zu sehen, ob die Bilder geladen sind.
Query Migrate ist eine Javascript-Bibliothek, die es Ihnen ermöglicht, die Kompatibilität Ihrer jQuery-Code für Versionen von jQuery älter als 1.9 entwickelt zu bewahren.
jQuery ist eine JavaScript-Bibliothek, eine kostenlose Open-Source-Software, die das Traversieren und Manipulieren des HTML-DOM-Baums sowie die Ereignisbehandlung, CSS-Animation und Ajax vereinfacht.
Lightbox ist eine kleine Javascript-Bibliothek, die verwendet wird, um Bilder über die aktuelle Seite zu legen.